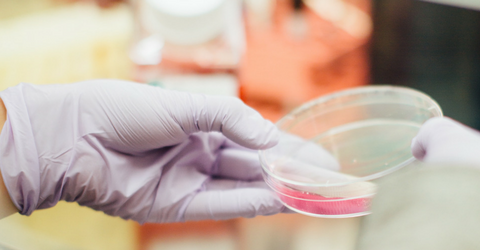

In order to help overcome your fertility struggle and start a family, it’s important for the specialists at the Kofinas Fertility Group in New York to have a complete understanding of the cause of your problems. Once we know the source of your fertility issues, we will design your treatment plan to directly address them and give you the best possible chance for a healthy, complication-free pregnancy.
We have decades of experience that inform our recommendations, and we always work with everyone we treat on a personal basis. It’s important to us to build a relationship with you, fully understand your struggle and give you the customized care you need to start a family. And because your assessment determines the entire course of your treatment, it’s important for us to be especially thorough in this facet of your care. You can trust that we will double-check all details, including those offered by FAFTA and conduct every assessment that will help us give you a better chance of experiencing the joy of parenthood.

In up to 20 percent of infertile couples, ovulation problems that prevent the woman from ovulating eggs (anovulation) are present. This makes performing an ovulatory function evaluation a crucial initial step when investigating the source of your infertility. By closely monitoring your ovulation cycle, the specialists at Kofinas Fertility Group in New York can detect improper functioning and give you targeted treatment to improve your fertility.
At the beginning of the menstrual cycle, an egg forms in the ovary. The eventual release of the egg is called ovulation. As the egg travels through the fallopian tubes into the uterus, the uterus produces the hormone progesterone to prepare the lining of the uterus for the implantation of a fertilized egg.
During your ovulatory function evaluation, we will perform one or more of the following tests in order to give us an accurate picture of your menstrual cycle:
After we perform the necessary tests, our insight into your ovulation cycle will allow us to proceed with the care that will best improve your fertility according to your specific needs. You and your future child are our primary concerns, and we will keep you fully informed of the meaning of your test results, as well as our rationale for the next step in your treatment.
Struggling to have a baby? Download our eBook full of tips!
For more information about our ovulatory function evaluation process, or to schedule an appointment, call 718-736-2218. You can also request an appointment using our easy online form.

At Kofinas Fertility Group in New York, we’re able to incorporate advanced imaging techniques into your fertility assessment process in order to give us a clear view of your reproductive system and identify any abnormalities that could be causing fertility issues. We purchase only the best equipment available and are well trained in its use, which allows us to collect the most accurate and useful diagnostic information possible. With a clear picture of your reproductive tract, we have a strong basis for identifying your problem, solving your fertility issues, and giving you the family you’ve always wanted.
Adhesions and abnormal growths, such as fibroids and polyps, can develop within the uterine cavity and cause or contribute to fertility problems. Using a noninvasive transvaginal ultrasound, our doctors can view the inside of your uterus in real-time and detect any abnormalities. And when we say “our doctors,” we mean that literally –– your fertility specialist will be the one performing your ultrasound, never a technician.
Because ultrasound waves develop a moving image, they are best viewed in real-time, not as still images provided to your physician after the exam. With our doctors controlling the ultrasound, they can control the focus of the images and investigate anything suspicious immediately during the exam.
Depending on where you are in your menstrual cycle (and if it is a normal 28-day cycle or not), other imaging techniques such as a hysterosalpingogram (HSG) and hysterosonogram (HSN) will be scheduled out in order to rule out any blockages in your uterus and/or fallopian tubes. This helps maintain the high-quality care standard set by Kofinas Fertility Group, and it contributes to our excellent diagnostic and treatment success.
An advanced imaging technique used by Kofinas Fertility Group is a hysterosalpingogram (HSG). By using a special form of x-ray called fluoroscopy and a contrast material, an HSG creates a live image of your uterus and fallopian tubes to help identify damage, blockages, abnormal uterus shape, and other potential problems with your fertility. Our doctors will fill your uterus with a radiographic contrast agent and watch its distribution via the X-ray image. By doing so, we can evaluate the function of your reproductive tract.
Another advanced imaging technique without the use of an x-ray is a hysterosonogram (HSN), or saline infusion sonogram. By infusing sterile fluid into the uterus, it allows our doctors to see if there are any obstructions or abnormalities preventing an embryo from attaching.
Finding out the cause(s) of your fertility problems in a precise, reliable manner is what’s most important to us during these exams. Every possible step will be taken to ensure your comfort while delivering accurate results. We will carefully walk you through each exam, and because we have some of the best talent available, you can trust us to figure out the optimal solution to your problems while giving you the compassionate care that we’re known for.
After your initial exam, the experts at Kofinas Fertility Group in New York will begin ruling out potential sources of your fertility problems. By examining different bodily fluids for any indicators of fertility interference, we can deliver targeted treatment in order to finally give you a successful pregnancy. Our specialists are well trained at examining the data collected from your samples, and they will review your results with you in a clear, accessible manner.
In order to streamline your care, you and your fertility specialist will go over the results together. By going over all the results with your fertility team during your discussion appointment, there’s no need to keep track of lots of individual results and will leave with an individualized treatment plan that brings you closer to achieving your goals.
We may need to test the lining of your uterus, called the endometrium, for any abnormalities that could be preventing a successful pregnancy. We conduct this test by removing a small sample of the endometrium and examining it under a microscope. The results will let our doctors know if your uterus is capable of sustaining a pregnancy. Depending on your individual problem, we offer many solutions, and finding one that meets your goals is both our expertise and our passion.
Another sample test that our fertility specialists perform is an endometrial biopsy. An endometrial biopsy is a test that that looks for inflammation (endometritis) and infections inside the uterus by inserting a thin, flexible tool to take a small tissue sample from the lining of your uterus (endometrium). The endometrial tissue is then viewed under a microscope to check for any abnormalities that may lead to failed IUI or IVF cycles in the future or may shed some light on failed attempts in the past.
A variety of hormone imbalances can contribute to infertility in both men and women. Through a simple blood test, we can check your hormone levels and evaluate the extent to which they’re affecting your fertility. Some of the hormones we look at include the following:
Your doctor will use your symptoms to determine the necessity of these tests. During each exam, you will be treated with the utmost professionalism and sensitivity — we understand the emotional stress that can be caused by fertility problems, and we’re confident that we can help you start the life you want and leave your uncertainty behind.
As male and female infertility tend to appear at equal rates, a semen analysis is a relatively simple test that we use to quickly eliminate or confirm possible sources of male fertility problems. You may either provide your semen sample at home or in one of our designated rooms at Kofinas Fertility Group, and we will analyze the sample in our on-site lab.
We check the following properties during your semen analysis:
If our analysis indicates any abnormalities, your skilled physician will work with you to create a personalized plan that addresses your needs.
Give us a call and talk to our team.